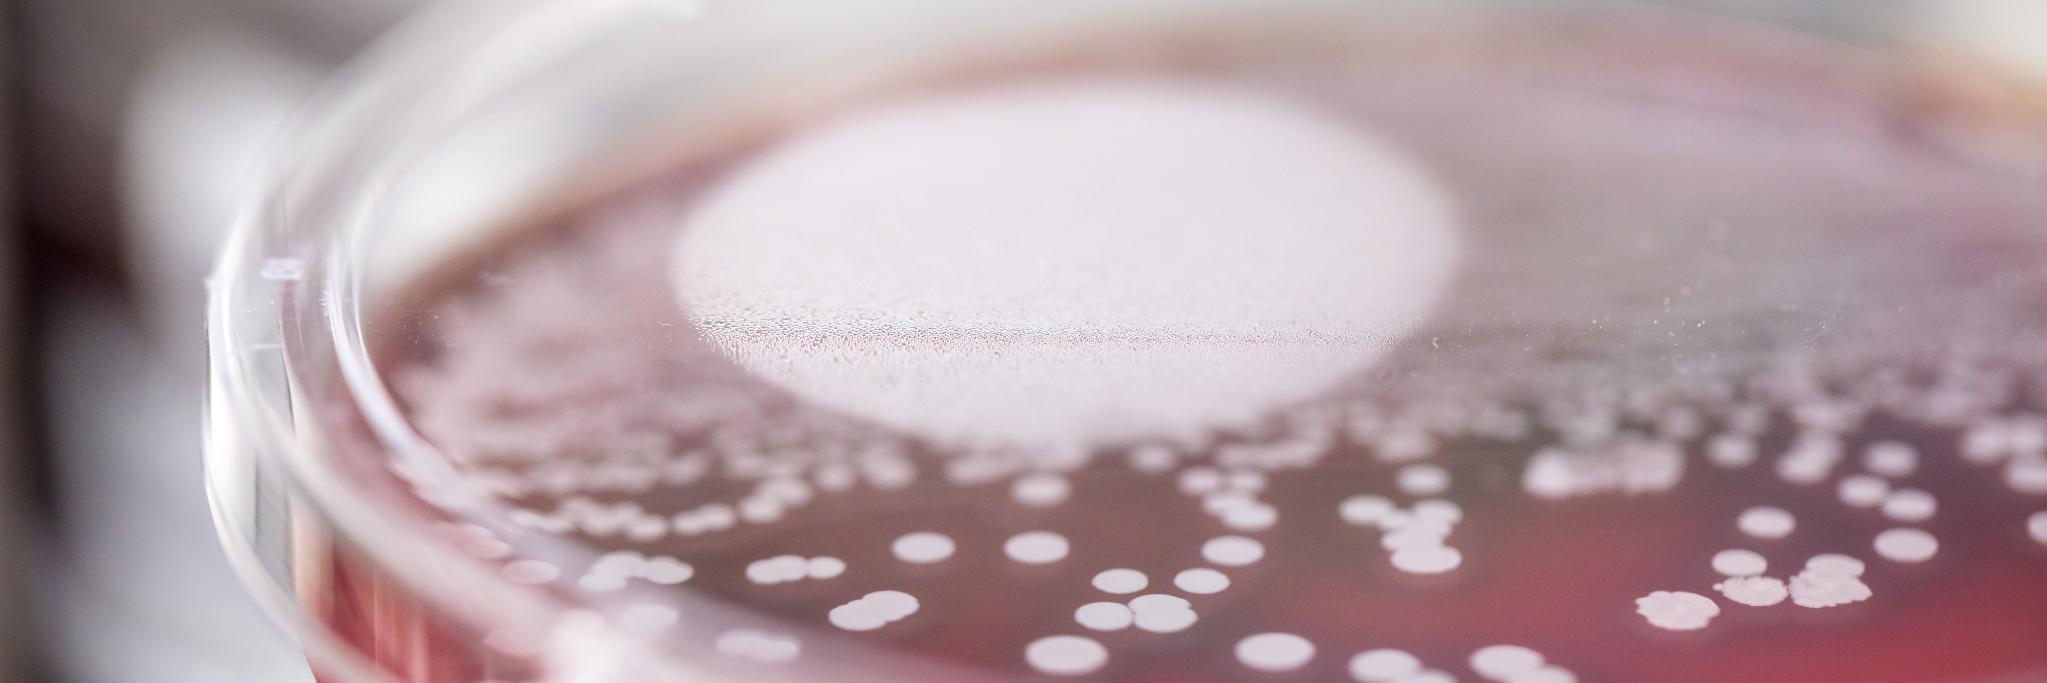
Carey-Ann Burnham banner

Carey-Ann Burnham
3K posts

@BurnhamBugDoc
Clinical Microbiologist. Runner. Traveler. Tweets are my own. CEO, Pattern Bioscience @Patternbio Professor of Pathology & Immunology @wusm_pathology






We've launched the ASM Health Scientific Unit, the first unit in our new strategic roadmap! By fostering interdisciplinary collaboration, ASM Health aims to advance microbial science for the benefit of society. Read more about the new unit: asm.social/2fF

Important leadership news at Pattern: Carey-Ann Burnham, our chief clinical officer since 2022, is now CEO! Founder Nick Arab transitions to CTO, focusing on advancing our single-cell microbiology tech. More details: pattern.bio/pattern-biosci…
















Dr. Virginia Pierce will present today at @ASCP_Chicago! Learn more about Selective and Cascade Reporting of Antimicrobial Susceptibility Testing Results to Improve Patient Care at her presentation. #UMichPath #ASCP24




🌟 Please join us in welcoming the first two Editors of @ASMCaseReports, Dr. Ritu Banerjee from @VUMCResearch and Dr. Nicholas Moore from @RushUniversity! 🌟 View the full Editorial Board: journals.asm.org/journal/asmcr/… @ASMicrobiology @ASMnewsroom @nmoore07 @BurnhamBugDoc

🌟 Please join us in welcoming the first two Editors of @ASMCaseReports, Dr. Ritu Banerjee from @VUMCResearch and Dr. Nicholas Moore from @RushUniversity! 🌟 View the full Editorial Board: journals.asm.org/journal/asmcr/… @ASMicrobiology @ASMnewsroom @nmoore07 @BurnhamBugDoc






ASM Journals is pleased to welcome @BurnhamBugDoc as the new editor in chief of our soon-to-launch fully open-access journal, ASM Case Reports. For more details on Dr. Burnham’s appointment, read the full press release: asm.social/1X6 #CaseReports